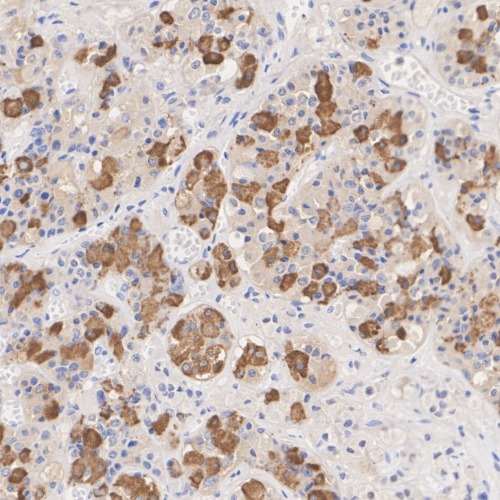

Luteinizing Hormone beta Rabbit Monoclonal Antibody(ARA949)
CAT.NO. : ARA6790
RMB Please choose
RMB Please choose
Size:
Trail, Bulk size or Custom requests Please contact us
*产品价格可能会有所调整,请以品牌方官网实时更新的价格为准,以确保准确性。
Background
Luteinizing hormone subunit beta also known as lutropin subunit beta or LHβ is a polypeptide that in association with an alpha subunit common to all gonadotropin hormones forms the reproductive signaling molecule luteinizing hormone. In humans it is encoded by the LHB gene. This gene is a member of the glycoprotein hormone beta chain family and encodes the beta subunit of luteinizing hormone (LH). Glycoprotein hormones are heterodimers consisting of a common alpha subunit and a unique beta subunit (this protein) which confers biological specificity. LH is expressed in the pituitary gland and promotes spermatogenesis and ovulation by stimulating the testes and ovaries to synthesize steroids.
Application
|
Application |
Dilution Ratio |
|
IHC-P |
1:1000-1:8000 |
Overview
|
Antibody Type |
Recombinant Rabbit Monoclonal Antibody |
|
Species Reactivity |
Human |
|
Validated Applications |
IHC-P |
|
Molecular Weight |
Predicted band size: 15 kDa |
|
Positive Control |
Human pituitary tissue |
|
Conjugation |
unconjugated |
|
Form |
Liquid |
|
Concentration |
1μg/ul |
|
Storage Buffer |
PBS (pH7.4), 0.1% BSA, 40% Glycerol. Preservative: 0.05% Sodium Azide |
|
Isotype |
IgG |
|
Purification Method |
Protein A affinity purified |
Data
Immunohistochemical staining of human pituitary tissue using Luteinizing Hormone beta Rabbit Monoclonal Antibody(ARA949)
Storage
Store at 4°C short term. For long term storage, store at -20°C, avoiding freeze/thaw cycles.
Research Use Only
For Research Use Only. Not for use in diagnostic procedures.
New Products
